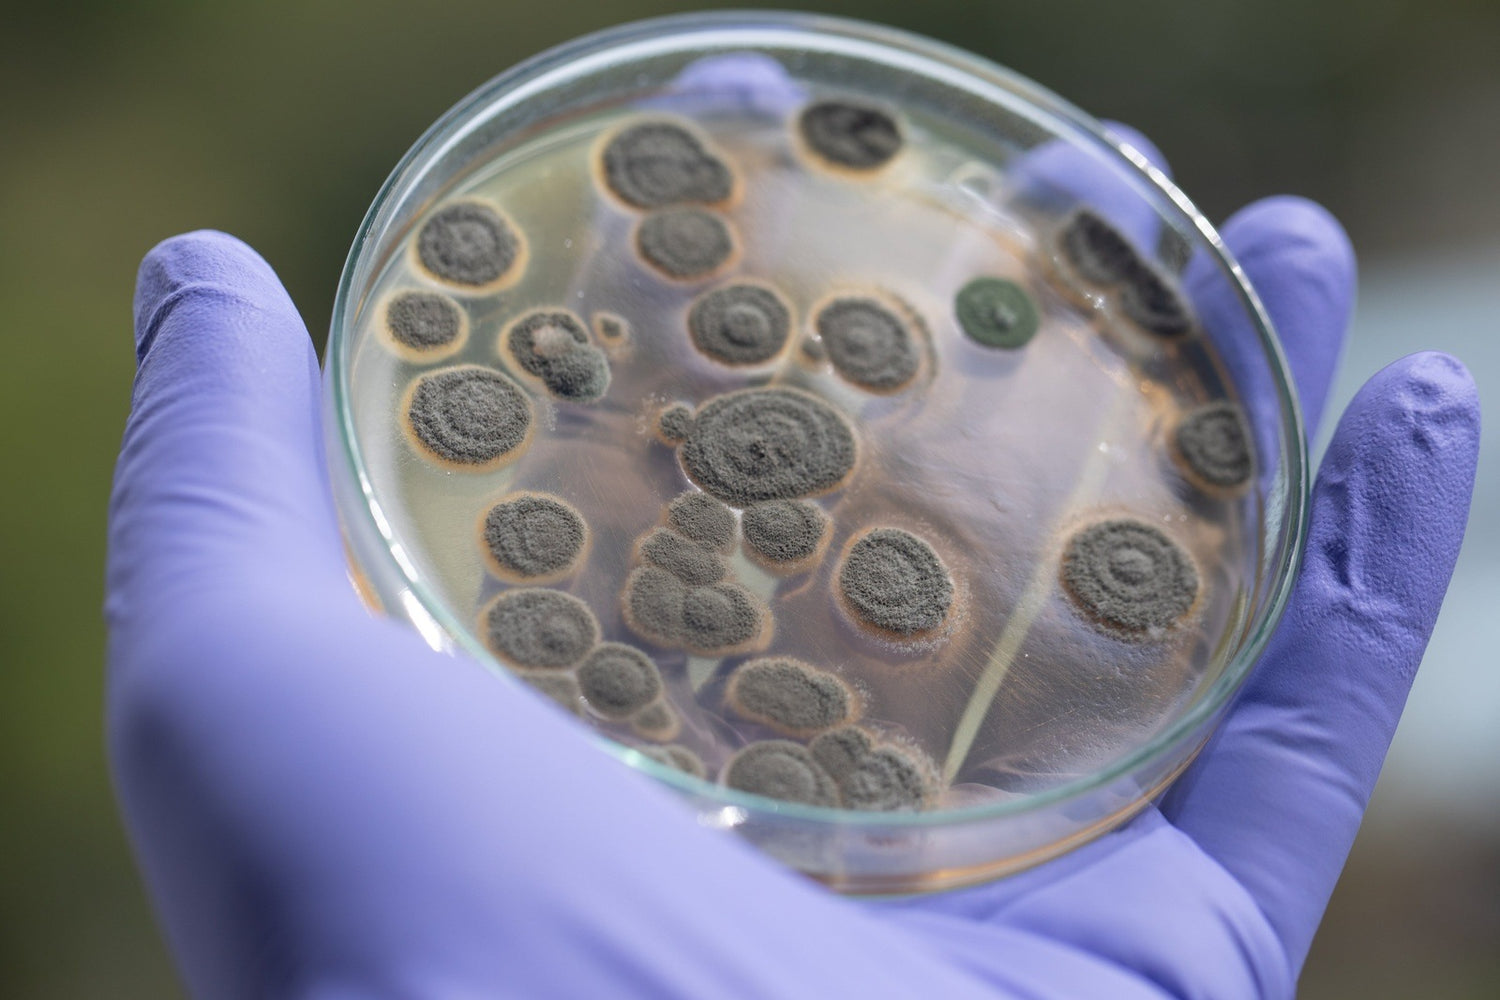

Is my house mouldy?
After you have worked out if you or a family member has mould illness, the next step is to find out where the mould exposure is coming from. Most often it is from your home, but it could also be from a workplace, school, or your vehicle.
Like testing your body, there are different options available which have pros and cons to each test. The end goal is to identify the source of the mould exposure so that it can be fixed.
For more information about what approaches we have seen work successfully, read our blog here

HAVE A LOOK
Sometimes it is very obvious you have a mould issue in your house. You can see the mould and damaged building materials (ie warped timber or wallpaper, stained patches in ceiling). Or you may have had a water event (ie flood, burst pipe, leak from roof). Remember- it doesn't have to be currently leaking or wet to be a problem. Dry mould and dead mould (mould fragments) can still cause problems!
This can be where it can be great to have a trained mould inspector or Building Biologist walk through and around your home to look for telltale signs that you have mould.
If you aren't sure who to hire to check your house out, read our blog which will give you tips on what questions to ask

GETTING CLEAR
Getting “clear” means removing yourself from the potential mouldy environment to see if your symptoms subside. If this happens then you can go back into that environment and look for any return or worsening of symptoms.
This can be quite a an effective way of working out what place is affecting you, but there also other variables that can impact you. For example you may also be sensitive to chemicals and EMF and this can confuse the results.
The other tricky part is finding a clean place to live temporarily. You may be lucky and a friend or relative has a house that is mould free, or you may go camping and find that you feel better (make sure your tent isn't mouldy, and if it's new let if offfgas for a while!)
MOULD TEST PLATES
These DIY mould plates are like a high school science experiment. You can either tap the plate against carpet, furnishings etc or leave sitting in a room for an hour. You then seal it up and put it in a dark, warm place for a few days and see what grows. They are very simple, and inexpensive but unfortunately they are not a reliable test. They won't pick up or grow all of the mould species in the air, and won't identify mould fragments or mycotoxins.
If you use this test and it comes back quite good, I wouldn't count on this as your only test to show your house is ok. On the other hand if your plate looks terrible then it is quite possible there is a mould problem, but you still want to do more testing to confirm.

AIR SAMPLING
This is the most common type of testing used by mould inspectors in New Zealand (and other countries). An air sample is usually taken from the center of a room and captures the amount and type of mould spores in the air- which is then tested and reported by a lab.
Some criticism of air sampling is that it can be unreliable if it is not close to the source of the mould (ie testing the middle of a room). This is because mould is not always producing spores at the same rate every day, air flow can fluctuate, and spores may be trapped behind a wall. It also won't pick up mould fragments or mycotoxins. If an inspector is taking air samples in a room, you want to make sure the house is closed up beforehand so the sample isnt diluted. They can also stir up the dust in the room to make the samples more accurate.
The inspector can also take a sample behind a wall, or closer to the potential problem, if they suspect water damage in that area. This can be more accurate as it will be closer to the source of the mould problem.
COST: Approx $150-$250 per sample. Plus cost of reporting and inspection time

TAPE LIFT, SWABS, OR PHYSICAL SAMPLE
This is where you either send a physical piece of the building material (ie gib, framing, flooring) to a lab,or use a piece of sellotape to take a sample off the material.
The lab then examines the sample under a microscope and reports on the species found (similar to air test). It can look at both dead and live mould which is useful.
There are local labs in NZ such as Biodet, Alpha Analytics and Eurofins who perform this, and it is great for testing specific areas to confirm if there is a mould problem
COST: Between $60-150 depending on the lab and sample type

DNA PCR TESTING
This is a dust sample and uses PCR technology (polymer chain reaction) to identify the mould species. The benefit of this test is that it looks at the mould over a longer period (of dust settling for weeks or months) and is also able to pick up mould fragments which can more easily escape from behind walls.
This is a great test to use as a screening test to see if there is a problem in your house. One test is enough for a normal sized home.
ERMI is a well known test for this but the score it gives isn't accurate. It needs to be intepreted by looking at the individual mould species present, and what levels they are.
COST: ERMI $240USD + intepretation/consult fee

MYCOTOXIN TESTING
These tests are able to identify 14 different mould toxin families. As mycotoxins can move through building materials much more easily than mould spores, this test may be more sensitive at picking up issues in your living space. This is also a dust test so can be used as a whole house screening test. The downside is that not all moulds produce mycotoxins, and it can be expensive to use both the PCR and mycotoxin testing together. If you someone is deciding between an ERMI and a Mycotoxin test, we will always suggest using the ERMI as it gives more relevant information
COST: $250 USD + shipping
What tests shall I do?
As you can see, there are lots of different tests available and each test has it's pros and cons. Which tests to use depends on your situation and budget.
We feel that there is a lot of value in having a qualified mould inspector or Building Biologist to look through your house as they may be able to help identify the sources of mould which is the end goal. If no one is in your area, We Inspect offer an online inspection service, as well as a inpection course called Moldfinders Method which teaches you how to inspect your own home.
In terms of testing, it depends on what question you are trying to answer. A screening test such as the ERMI test (with or without mycotoxin test) can help identify if there is a general problem in your house- but it won't tell you where it is coming from. To find our where the source is, a mould inspector can use their inspection skills and may use air or physical sampling to test the areas that could potentially be the source of the mould exposure.
If your house has obvious mould problems, and you are planning on moving then you may not need any testing. But it is a good idea to test, or at least inspect, the house that you are planning on moving into even if it looks good on the surface (even new builds can have problems!).
Like many things with mould illness, there is a lot of information to consider and decisions to make. If you would like some help in determining what testing is right for your situation, you can book a support call with us.